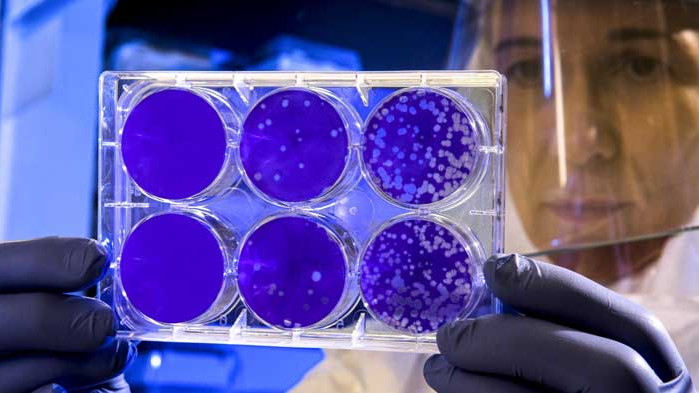
Варна с антирекорд - 61 нови случая на COVID-19, общо за страната са 119

Варна<+> 03.08.2020 00:45 Снимка: ДНЕС+
Варна с антирекорд - 61 нови случая на COVID-19, общо за страната са 119
119 са новодиагностицираните с COVID-19 лица през последното денонощие. За изминалите 24 часа са направени 1491 PCR теста.
Близо 8% от изследваните проби са дали положителен резултат за наличие на инфекция. Това сочат данните в Националната информационна система.
61 от новите случаи са установени при лица с постоянно местожителство във Варна.
В Добрич са регистрирани 13 положителни проби, в София и Пловдив - по 8.
В областите Велико Търново, Кърджали, Ловеч, Монтана, Перник, Разград, Силистра, София област, Търговище и Шумен няма нови положителни проби. В останалите области на страната са установени единични нови случаи на заразата.

11955 са общо доказаните случаи на новия коронавирус у нас. От тях активни към момента са 5147.
Излекуваните лица са 6420, от които 24 са регистрирани през изминалото денонощие.
С доказан COVID-19 в лечебни заведения за болнична помощ се намират 814 пациенти. 46 от тях са настанени в интензивни структури.
| Област | Общо | Нови |
| Благоевград | 746 | 1 |
| Бургас | 334 | 1 |
| Варна | 791 | 61 |
| Велико Търново | 242 | - |
| Видин | 235 | 3 |
| Враца | 78 | 2 |
| Габрово | 135 | 2 |
| Добрич | 344 | 13 |
| Кърджали | 135 | - |
| Кюстендил | 509 | 4 |
| Ловеч | 37 | - |
| Монтана | 49 | - |
| Пазарджик | 494 | 1 |
| Перник | 143 | - |
| Плевен | 392 | 2 |
| Пловдив | 924 | 8 |
| Разград | 114 | - |
| Русе | 238 | 3 |
| Силистра | 45 | - |
| Сливен | 400 | 3 |
| Смолян | 470 | 4 |
| София | 566 | - |
| София (столица) | 3708 | 8 |
| Стара Загора | 276 | 1 |
| Търговище | 31 | - |
| Хасково | 93 | 1 |
| Шумен | 173 | - |
| Ямбол | 253 | 1 |
| ОБЩО | 11955 | 119 |
Според Националната информационна система при 691 медицински служители у нас е констатирана коронавирусна инфекция. Седем са новите случаи, регистрирани през последните 24 часа.
Починалите лица, при които е бил потвърден новият коронавирус, са 388. Три от случаите са от изминалото денонощие.
Ден по-рано у нас бяха регистрирани 146 нови случая на COVID-19.
Още по темата
 CHF
CHF
|
1 | 2.10463 |
 GBP
GBP
|
1 | 2.24498 |
 RON
RON
|
10 | 3.83729 |
 TRY
TRY
|
100 | 3.87564 |
 USD
USD
|
1 | 1.66355 |
Последни новини
- 20:25 Йосиф Миладинов: Една мечта се сбъдна
- 20:17 Четири навика, които ни пречат да пестим
- 20:08 Опашки от коли на "Дунав мост 1"
- 20:00 Руски боен самолет се разби в Охотско море, пилотът е оцелял
- 19:50 Пунктът "Рудозем-Ксанти" ще заработи до края на годината, според Стефан Янев
- 19:38 Кандидатът за канцлер в Германия изпитва дълбок срам заради Втората световна война
- 19:30 Астън Вила уреди заместник на Грийлиш
- 19:18 Пянич иска да се върне в Ювентус





